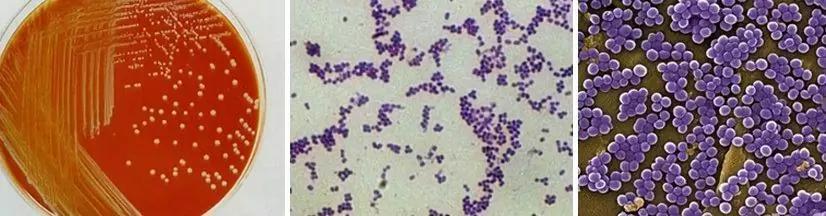
猪得葡萄球菌皮肤病,葡萄球菌引起的猪渗出性皮炎

仔猪渗出性皮炎又称脂溢性皮炎、油性皮肤病。它是一种高度接触传染病的拥有属性油性分泌物,能渗出皮肤表皮的剥落,形成小水泡,并在表皮上结痂。该病的发生季节性不明显,可全年发生,为散发性,发病率一般为2% ~ 5% ,环境恶劣的猪场发病率在10% 以上,如果存在免疫抑制性病原体如环状感染,死亡率可高达70% 。该病的耐受性、恢复性、生长受到严重阻碍,部分生猪发生生长僵硬,造成巨大的经济损失。
临床症状
临床以7-15日龄仔猪多见,偶尔断奶后,最早可在2-3日龄开始。在疾病的早期,口腔和脸部周围的皮肤出现红斑和水泡。如果控制不好,水泡很快就会扩散到背部和腹部。水泡破裂后,粘稠的液体渗出,渗出部位变成黑色并结痂,甚至可能遍布全身。结痂的皮肤裂缝处,有粘液从裂缝中渗出,伴有腹泻、消瘦等症状,严重脱水,死亡快。

病原
猪病包括葡萄球菌、松鼠葡萄球菌、表皮葡萄球菌金黄色葡萄球菌、假中间型葡萄球菌、革兰氏染色阳性葡萄球菌。该菌在琼脂板上呈圆凸形,边缘整齐,表面光滑,潮湿,不透明,呈球形或微椭圆形,直径约1.0微米,呈葡萄状排列。这些病原体广泛存在于环境中,难以清除,在猪体表广泛存在,一般情况下不具有致病性。葡萄球菌对环境有较强的耐药性,可在干燥的脓液和血液中存活2-3个月。在摄氏80度的环境下,火需要30分钟才能熄灭,但煮沸可以迅速杀死它,而且可以被普通消毒剂杀死,这些消毒剂对磺胺类药物、-内酰胺和大环内酯类药物敏感,但对抗药性敏感。
发病原因
葡萄球菌具有自然疫源性,普遍存在于环境中,所以容易感染猪只。
1.新生仔猪,脐带断裂做好消毒,葡萄球菌就很容易通过脐带感染;
2.断尾或剪牙时伤到牙床,或剪牙晚弄伤嘴,葡萄球菌容易从伤口感染;

3.哺乳仔猪打斗抢奶的时候,皮肤划伤,葡萄球菌容易通过伤口感染;

4.哺乳期仔猪打疫苗,伤口处理不当,消毒不严格,导致感染;
5.当母猪奶水缺少时,仔猪用力拱地膝盖磨破,葡萄球菌容易感染;

6.产房环境潮湿,脏乱差、容易引发仔猪湿疹及寄生虫感染,仔猪蹭痒容易擦伤皮肤,葡萄球菌容易感染
预防措施
1、产房消毒必须规范、彻底,环境尽可能干燥,做好母猪的除虫工作;。
2、分娩时应注意器械和人员的消毒,严格消毒脐带和新生仔猪断尾,断尾应涂碘,初乳应肌肉注射长效头孢菌素、抗菌、抗炎,并注意断牙操作。
3、做好母猪的饲养管理,提供充足的营养,促进母猪乳腺的发育,提高产奶量,做好仔猪乳头的固定,根据仔猪的大小和力量调整哺乳乳头的位置,以防发生乳头争斗。体质较弱的仔猪应尽量放在前三对乳头内,以保证仔猪个体的均衡生长发育。
4、给刀具消毒,处理好伤口。
5、做好母猪疫苗接种工作,提供优质的母乳,优质的初乳可以提高仔猪抗感染的能力。
治疗
1、如伤口严重感染,可用来苏水(1%-2%)或高锰酸钾水(0.1%)浸泡伤口,如伤口严重感染,可用过氧化氢冲洗伤口并涂上碘,然后涂抹红霉素软膏,再配以真菌病,加入灰*霉素黄**或松弛皮肤。给他用头孢菌素,林可霉素和地塞米松,一天一次,两到三天。
2、严重的疾病没有治疗价值的淘汰。
总结
要减少葡萄球菌性脂溢性皮炎的出现,应从环境卫生、消毒、饲养管理和疾病预防及控制等方面着手,预防和控制葡萄球菌。